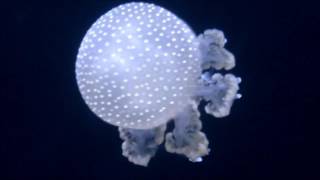
Thomas Newman – Ghosts

Song info
"Aurora"
(2016)
on the album Passengers [Original Motion Picture Soundtrack](2016).
0 người yêu thích
"Aurora" Videos
Lyrics
Oh! We don't have the lyrics to this song yet.
- 0 Bản dịch
Albums has song "Aurora"
![Passengers [Original Motion Picture Soundtrack]](http://netstorage.metrolyrics.com/albums/2016/12/6850118jpg.jpg)
Passengers [Original Motion Picture Soundtrack]
2016 20 songs
- The Starship Avalon [Main Title] 2016
- Spacewalk 2016
- Hibernation Pod 1625 2016
- Command Ring 2016
- Rate 2 Mechanic 2016
- Awake for 7 Days 2016
- Crystalline 2016
- Precious Metals 2016
- Aurora 2016
- Robot Questions 2016
- The Sleeping Girl 2016
- Build a House and Live in It 2016
- I Tried Not To... 2016
- Passengers 2016
- 50% of Light Speed 2016
- Cascade Failure 2016
- Zero-Gravity 2016
- Never Happy Here 2016
- Red Giant 2016
- Looking for Wrong 2016

Recent comments